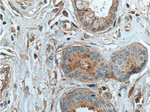
THSD4 Antibody in Immunohistochemistry (Paraffin) (IHC (P))

Search
Proteintech
THSD4 Polyclonal Antibody
{{$productOrderCtrl.translations['antibody.pdp.commerceCard.promotion.promotions']}}
{{$productOrderCtrl.translations['antibody.pdp.commerceCard.promotion.viewpromo']}}
{{$productOrderCtrl.translations['antibody.pdp.commerceCard.promotion.promocode']}}: {{promo.promoCode}} {{promo.promoTitle}} {{promo.promoDescription}}. {{$productOrderCtrl.translations['antibody.pdp.commerceCard.promotion.learnmore']}}
产品信息
20619-1-AP
种属反应
宿主/亚型
分类
类型
抗原
偶联物
形式
浓度
规格
纯化类型
保存液
内含物
保存条件
运输条件
产品详细信息
Immunogen sequence: SAQTFPVRH PDRFSPHRPD NLVPPAPQPP RRSRDHNWKQ LGTTECSTTC GKGSQYPIFR CVHRSTHEEA PESYCDSSMK PTPEEEPCNI FPCPAFWDIG EWSECSKTCG LGMQHRQVLC RQVYANRSLT VQPYRCQHLE KPETTSTCQL KICSEWQIRT DWTSCSVPCG VGQRTRDVKC VSNIGDVVDD EECNMKLRPN DIENCDMGPC AKSWFLTEWS ERCSAECGAG VRTRSVVCMT NHVSSLPLEG CGNNRPAEAT PCDNGPCTGK VEWFAGSWSQ CSIECGSGTQ QREVICVRKN ADTFEVLDPS ECSFLEKPPS QQSCHLKPCG AKWFSTEWSM SLQRAMLTRP S (669-1018 aa encoded by BC008840)
仅用于科研。不用于诊断过程。未经明确授权不得转售。
生物信息学
蛋白别名: A disintegrin and metalloproteinase with thrombospondin motifs-like protein 6; ADAMTS-like protein 6; Thrombospondin type-1 domain-containing protein 4; thrombospondin, type I, domain containing 4; unnamed protein product
基因别名: AAT12; ADAMTSL-6; ADAMTSL6; FVSY9334; PRO34005; THSD4; UNQ9334/PRO34005
UniProt ID: (Human) Q6ZMP0
Entrez Gene ID: (Human) 79875